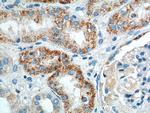
GPR116 Antibody in Immunohistochemistry (Paraffin) (IHC (P))

Search
Proteintech
GPR116 Polyclonal Antibody
{{$productOrderCtrl.translations['antibody.pdp.commerceCard.promotion.promotions']}}
{{$productOrderCtrl.translations['antibody.pdp.commerceCard.promotion.viewpromo']}}
{{$productOrderCtrl.translations['antibody.pdp.commerceCard.promotion.promocode']}}: {{promo.promoCode}} {{promo.promoTitle}} {{promo.promoDescription}}. {{$productOrderCtrl.translations['antibody.pdp.commerceCard.promotion.learnmore']}}
产品信息
14047-1-AP
种属反应
已发表种属
宿主/亚型
分类
类型
抗原
偶联物
形式
浓度
规格
纯化类型
保存液
内含物
保存条件
运输条件
产品详细信息
Immunogen sequence: PLSLHEHEP AGEEALRQKR AVATKSPTAE EYTVNIEISF ENASFLDPIK AYLNSLSFPI HGNNTDQITD ILSINVTTVC RPAGNEIWCS CETGYGWPRE RCLHNLICQE RDVFLPGHHC SCLKELPPNG PFCLLQEDVT LNMRVRLNVG FQEDLMNTSS ALYRSYKTDL ETAFRKGYGI LPGFKGVTVT GFKSGSVVVT YEVKTTPPSL ELIHKANEQV VQSLNQTYKM DYNSFQAVTI NESNFFVTPE IIFEGDTVSL VCEKEVLSSN VSWRYEEQQL EIQNSSRFSI YTALFNNMTS VSKLTIHNIT PGDAGEYVC (33-350 aa encoded by BC066121)
靶标信息
G protein-coupled receptors (GPRs), also known as seven transmembrane receptors, heptahelical receptors or 7TM receptors, comprise a superfamily of proteins that play a role in many different stimulus-response pathways. G protein coupled receptors translate extracellular signals into intracellular signals (G protein activation) and they respond to a variety of signaling molecules, such as hormones and neurotransmitters. GPR116 (G protein-coupled receptor 116) is a 1,346 amino acid multi-pass membrane protein that contains one SEA domain, one GPS domain and three Ig-like domains and belongs to the GPR family. Existing as a dilsulfide-liked homodimer at the cell surface, GPR116 exists as multiple alternatively spliced isoforms and is thought to play a role in regulating and maintaining proper acid-base balance throughout the cell.
仅用于科研。不用于诊断过程。未经明确授权不得转售。
生物信息学
蛋白别名: Adhesion G protein-coupled receptor F5; DKFZp564O1923; FLJ90640; G-protein coupled receptor 116; Ig-Hepta homolog; probable G-protein coupled receptor 116; unnamed protein product
基因别名: ADGRF5; GPR116; KIAA0758; KPG_001
UniProt ID: (Human) Q8IZF2
Entrez Gene ID: (Human) 221395